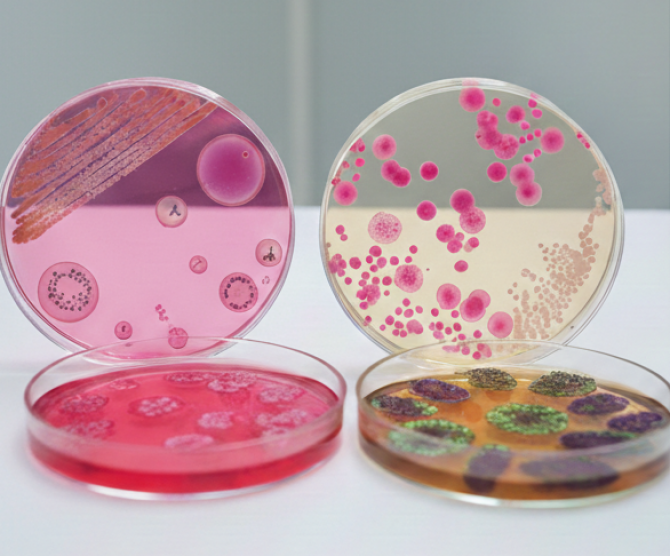
Besiyeri

Asgen Biomedikal
Asgen Biomedikal, Medikal Cihaz, Sarf
Malzemeleri ve Sağlık Çözümleri
Asgen Biomedikal, sağlık sektöründe medikal cihaz, medikal
sarf malzemeleri ve laboratuvar ürünleri alanlarında faaliyet gösteren,
uzmanlık ve güven odaklı bir medikal firmadır. Kurulduğu günden bu yana;
oftalmoloji, tüp bebek (IVF), mikrobiyoloji, patoloji ve laboratuvar çözümleri
başta olmak üzere farklı disiplinlerde hastaneler, özel klinikler ve
laboratuvarlara yönelik profesyonel çözümler sunmaktadır.
Türkiye genelinde yaygın bir müşteri ağına hizmet veren Asgen
Biomedikal, sağlık profesyonellerinin ihtiyaçlarını yakından takip ederek,
klinik ve laboratuvar süreçlerini destekleyen, güvenilir ve uluslararası
standartlara uygun ürünleri sektöre kazandırmaktadır.
Uluslararası
Medikal Markaların Türkiye Temsilcisi
Asgen Biomedikal, alanında uluslararası kalite standartlarına
sahip üretici firmaların Türkiye temsilciliklerini ve distribütörlüğünü
yürütmektedir. Temsil edilen markalar; ürün güvenilirliği, klinik ve
laboratuvar performansı, hasta güvenliği ve sürdürülebilir üretim kriterleri
doğrultusunda titizlikle seçilmektedir.
Bunlar arasında:Lucidis, Tekia, Purelon, Sidapharm, Teknomek,
Haag-Streit, TowardPi, iCARE, MediWorks. Moptim, MEDA, Lightmed, i-Optik,
Crystalvue, SK Med, Simuleye, Rheon, Oculera, Beslab, TechBruein ve
Santamed yer almaktadır.
Bu iş birlikleri sayesinde; dünya genelinde kabul görmüş
medikal ve laboratuvar ürünleri Türkiye’deki sağlık kuruluşlarına sunulmakta,
satış öncesi danışmanlık, ürün bilgilendirme, teknik destek ve satış sonrası
hizmetlerle sürecin her aşamasında etkin destek sağlanmaktadır.
Faaliyet
Alanlarımız
Oftalmoloji
(Göz Sağlığı)
Göz sağlığı alanında; göz içi lensler, oftalmik cerrahi sarf
malzemeleri ve oftalmolojiye yönelik medikal cihazlar ile göz cerrahlarının
klinik ihtiyaçlarına kapsamlı çözümler sunuyoruz.
Tüp Bebek
(IVF) Medikal Ürünleri
IVF merkezleri ve embriyoloji laboratuvarları için yüksek
hassasiyet gerektiren tüp bebek sarf malzemeleri, embriyoloji ürünleri ve
laboratuvar ekipmanları ile reprodüktif tıp süreçlerini güvenle destekliyoruz.
Mikrobiyoloji
ve Laboratuvar Çözümleri
Mikrobiyoloji laboratuvarlarında kullanılan kültür
besiyerleri, laboratuvar sarf malzemeleri ve tanı süreçlerine yönelik ürünlerle
doğru ve güvenilir analizlerin gerçekleştirilmesine katkı sağlıyoruz.
Patoloji
Çözümleri
Patoloji laboratuvarları için; doku takibi, örnek hazırlama
ve analiz süreçlerinde kullanılan patoloji sarf malzemeleri ve laboratuvar
ürünleri ile doğru tanı süreçlerini destekleyen çözümler sunmaktayız.
Ortopedi ve
Fizik Tedavi (FTR)
Ortopedi ve fizik tedavi alanlarında kullanılan medikal
ürünlerle hasta konforunu artıran ve tedavi etkinliğini destekleyen çözümler
sağlamaktayız.
Hizmet
Anlayışımız
Asgen Biomedikal, ürün tedarik süreçlerini yalnızca lojistik
bir hizmet olarak değil, sağlık kuruluşları için bütüncül bir çözüm süreci
olarak ele alır. Satış öncesi danışmanlık, ürün bilgilendirme, teknik destek ve
satış sonrası hizmetlerle sağlık profesyonellerinin her aşamada yanında yer
alır.
Misyonumuz
Uluslararası alanda da hizmet veren firmamız, çalışmalarında
sadece ürünlerini pazarlamayı değil aynı zamanda çözümün bir parçası olmayı ve
müşterilerinin memnuniyetini en üst düzeyde sağlamayı ilke edinmiştir.
Vizyonumuz
Nitelikli, güvenli ve ekonomik ürün ilkesinden asla
vazgeçmeden, etik değerlerden ödün vermeyerek, müşterilerimize kaliteli hizmet
vermeye devam edeceğiz.
Asgen Biomedikal ile sağlıkta kalite, güven ve yenilik bir arada.
Referanslar

Yalova Devlet Hastanesi

Vakfıkebir Devlet Hastanesi

Ümraniye Eğitim Araştırma Hastanesi

Zonguldak Uzun Mehmet Devlet Hastanesi

Uşak Devlet Hastanesi

Turhal Devlet Hastanesi